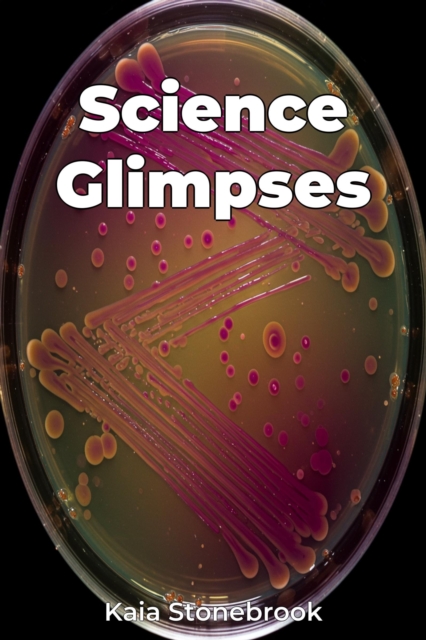
Science Glimpses

Science Glimpses
Science Glimpses explores the captivating realm of scientific discovery, revealing how seemingly minor observations have sparked major breakthroughs throughout history.
It emphasizes the pivotal role of observation, curiosity, and even serendipity in science history, proving that progress isn''t always a linear march of planned experiments.
For example, the book elucidates how the accidental observa...
Science Glimpses explores the captivating realm of scientific discovery, revealing how seemingly minor observations have sparked major breakthroughs throughout history.
It emphasizes the pivotal role of observation, curiosity, and even serendipity in science history, proving that progress isn''t always a linear march of planned experiments.
For example, the book elucidates how the accidental observa...
